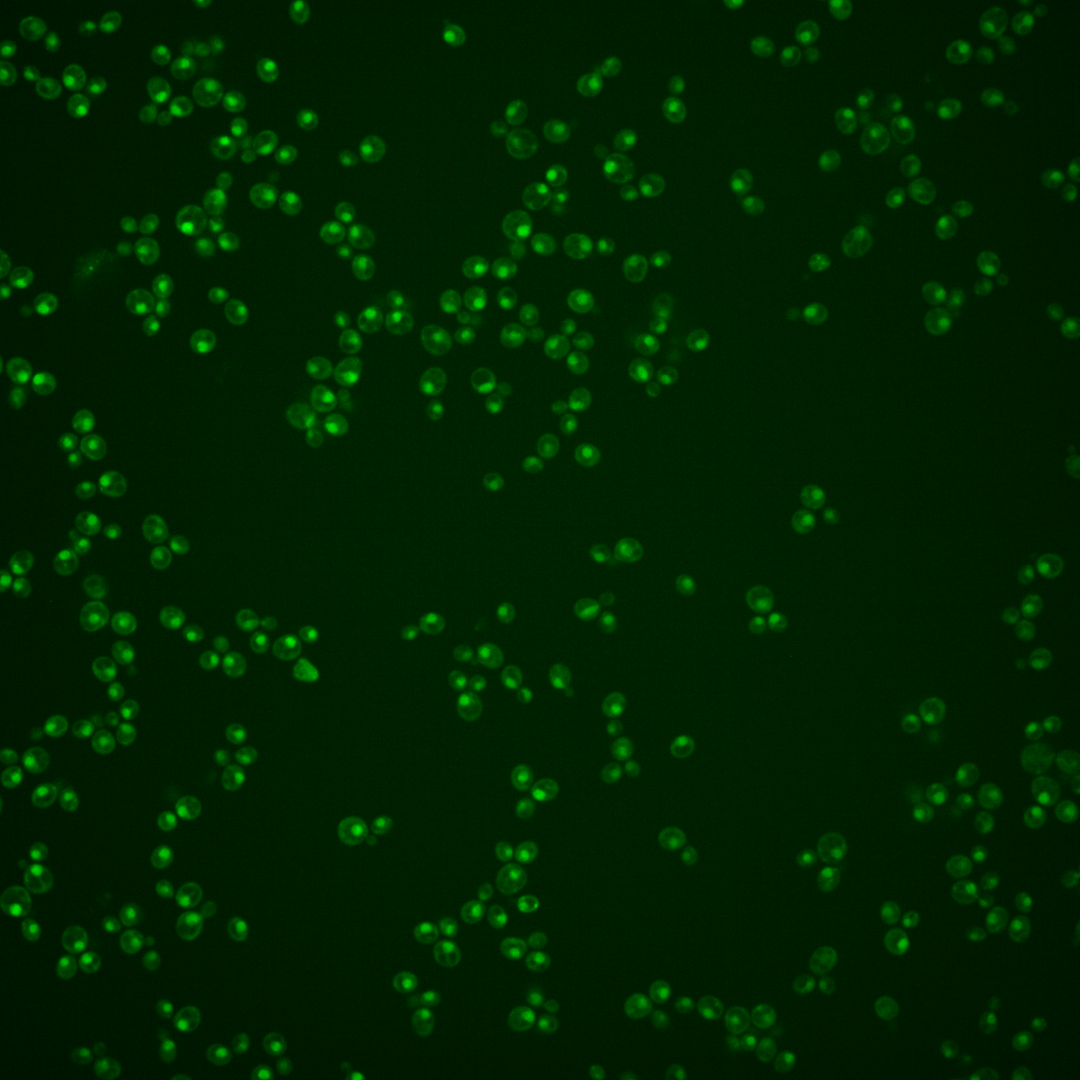
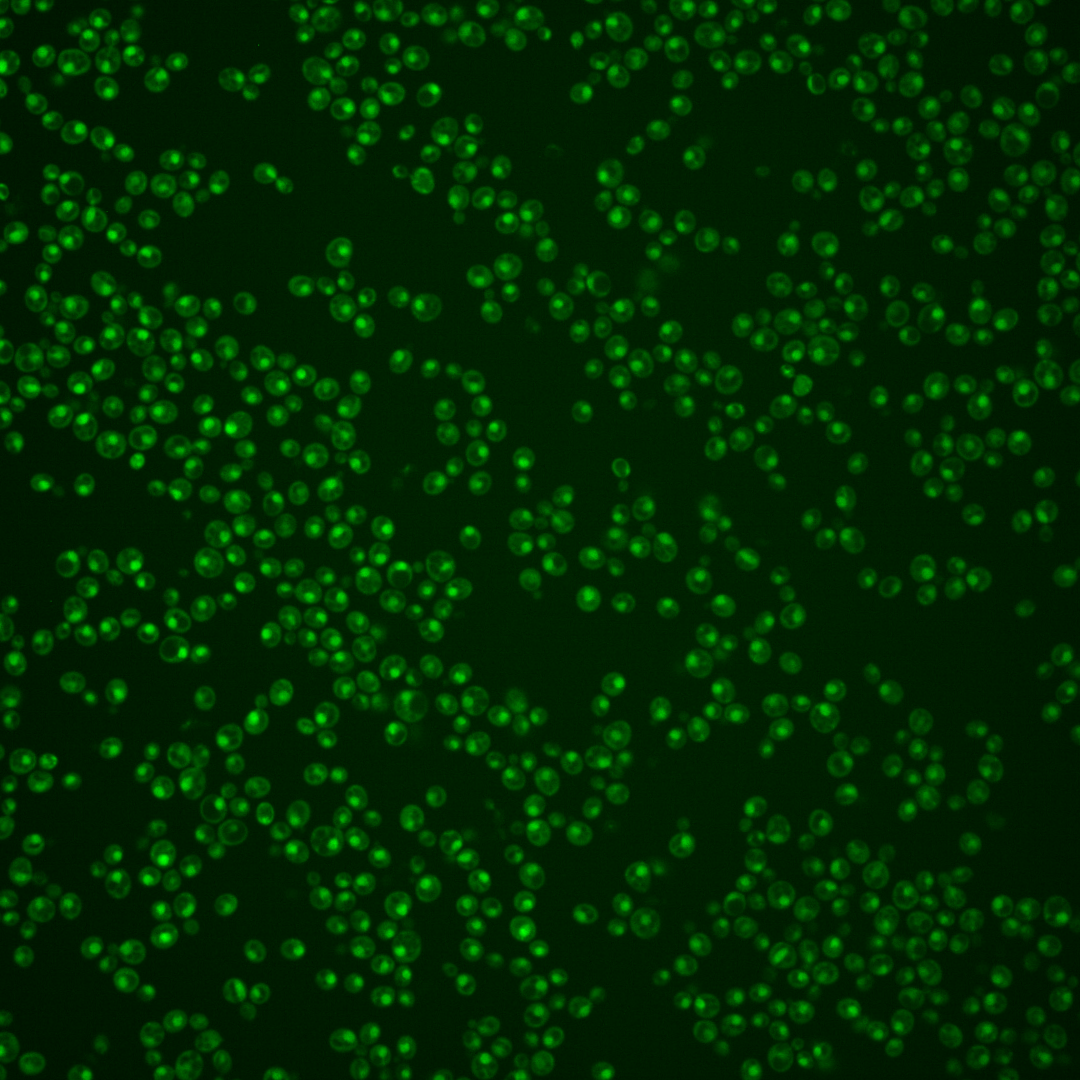
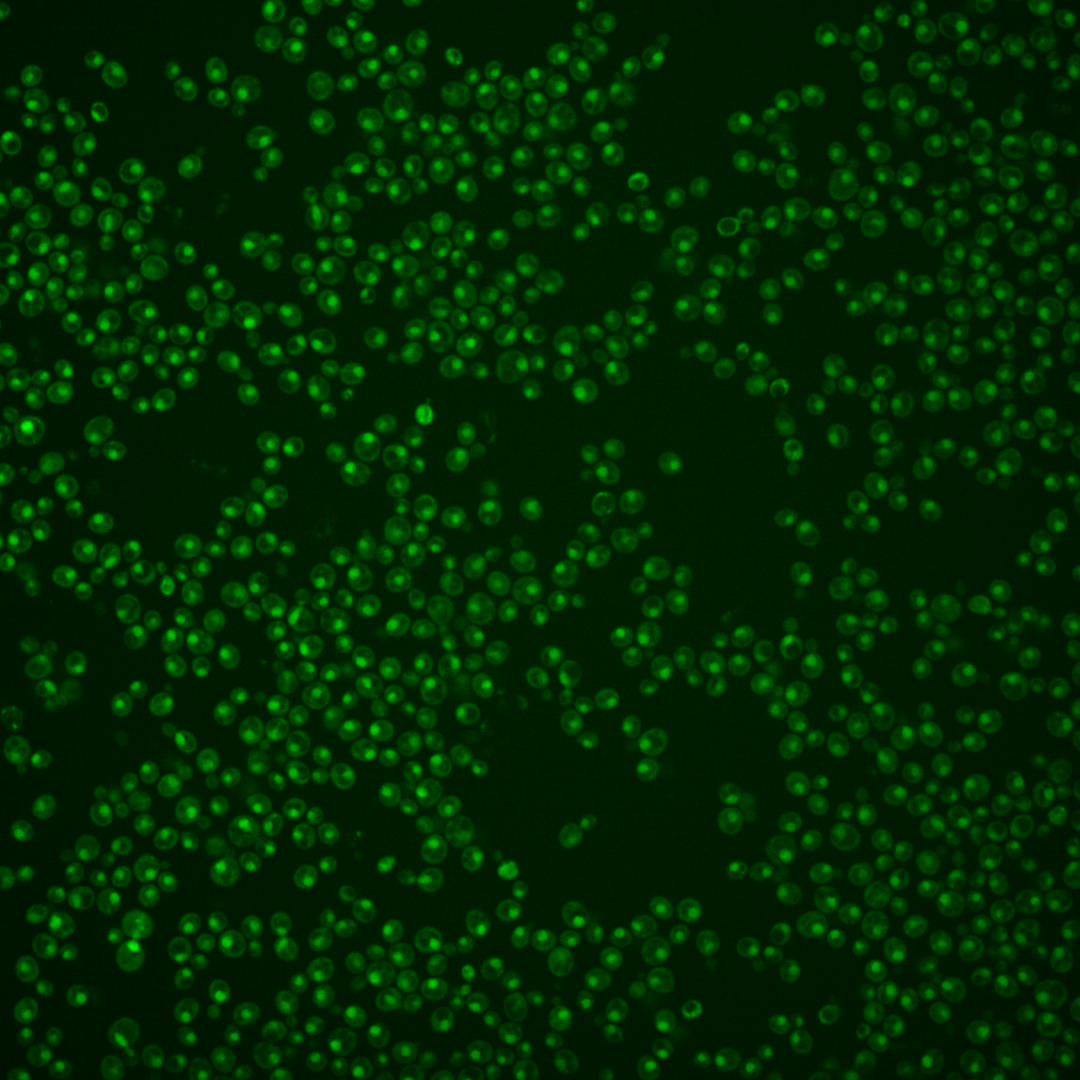
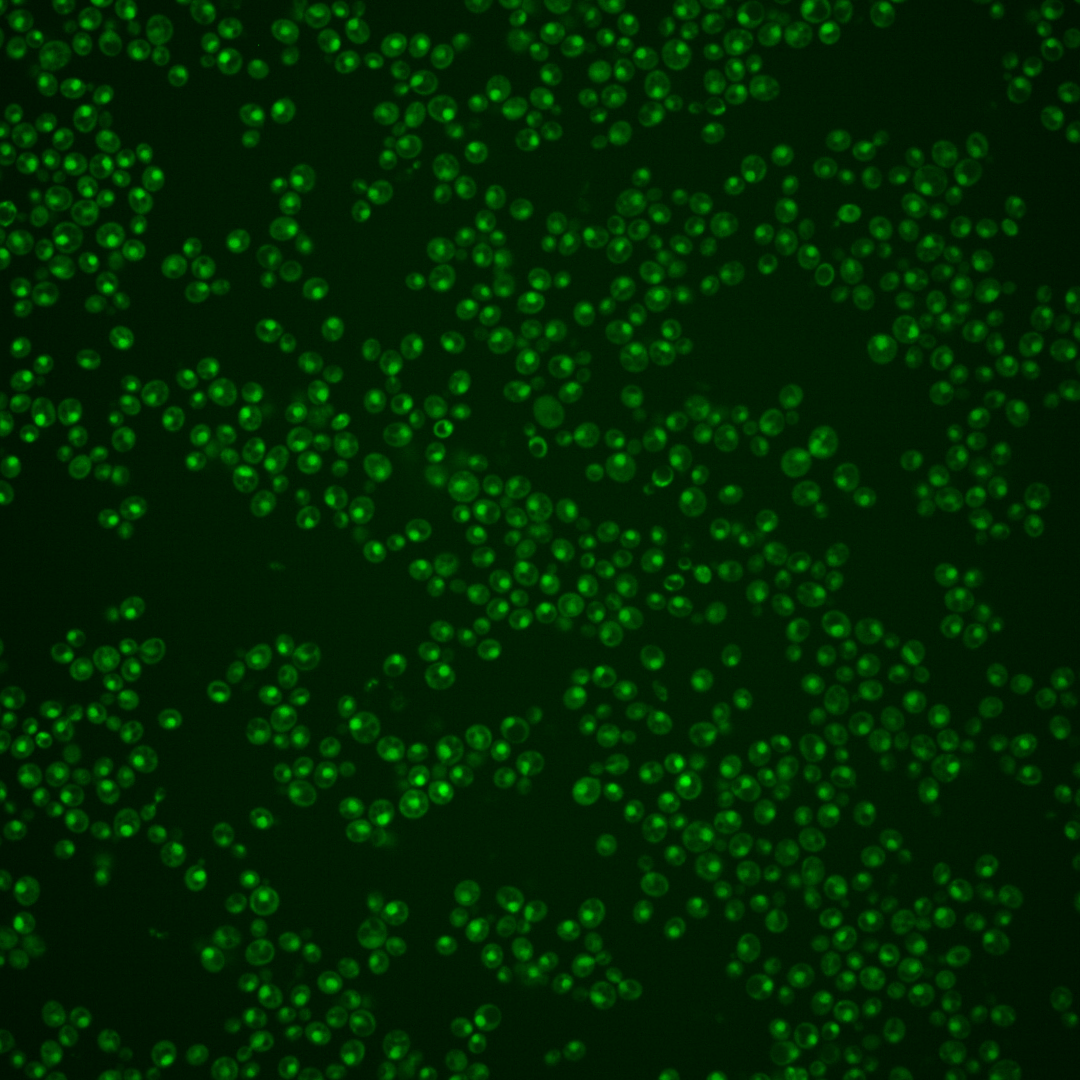

| Standard name | |
|---|---|
| Human Ortholog | |
| Description | Member of the NineTeen Complex (NTC); this complex contains Prp19p and stabilizes U6 snRNA in catalytic forms of the spliceosome containing U2, U5, and U6 snRNAs; binds directly to U6 snRNA; similar to S. pombe Cwf2 |
Micrographs




















































































Sub-cellular Localization
Yeast GFP Assignment
Protein Abundance
Localization Change
External localization resources
| ensLOC | DeepLoc | |||||||||||||||||||||||
|---|---|---|---|---|---|---|---|---|---|---|---|---|---|---|---|---|---|---|---|---|---|---|---|---|
| Localization | WT1 | WT2 | WT3 | RAP60 | RAP140 | RAP220 | RAP300 | RAP380 | RAP460 | RAP540 | RAP620 | RAP700 | HU80 | HU120 | HU160 | rpd3Δ_1 | rpd3Δ_2 | rpd3Δ_3 | WT1 | WT2 | WT3 | AF100 | AF140 | AF180 |
| Cortical Patches | 0 | 0 | 0 | 0 | 0 | 0 | 0 | 0 | 0 | 0 | 0 | 0 | 0 | 0 | 0 | 0 | 0 | 0 | 0 | 0 | 0 | 0 | 1 | 1 |
| Bud | 1 | 0 | 0 | 1 | 0 | 0 | 4 | 2 | 4 | 1 | 7 | 2 | 0 | 0 | 0 | 0 | 0 | 0 | 3 | 1 | 1 | 1 | 7 | 8 |
| Bud Neck | 0 | 0 | 1 | 0 | 0 | 0 | 0 | 2 | 0 | 2 | 1 | 0 | 2 | 0 | 0 | 0 | 0 | 0 | 0 | 0 | 0 | 0 | 2 | 3 |
| Bud Site | 0 | 0 | 0 | 0 | 4 | 7 | 11 | 11 | 9 | 10 | 21 | 14 | 0 | 0 | 0 | 0 | 0 | 0 | – | – | – | – | – | – |
| Cell Periphery | 0 | 0 | 0 | 0 | 0 | 0 | 0 | 0 | 0 | 1 | 0 | 0 | 0 | 0 | 1 | 0 | 0 | 0 | 0 | 0 | 0 | 0 | 0 | 0 |
| Cytoplasm | 3 | 4 | 16 | 20 | 25 | 24 | 23 | 24 | 20 | 19 | 21 | 10 | 39 | 79 | 90 | 7 | 9 | 9 | 1 | 1 | 1 | 2 | 5 | 3 |
| Endoplasmic Reticulum | 0 | 0 | 1 | 1 | 1 | 0 | 0 | 0 | 0 | 0 | 0 | 0 | 3 | 0 | 1 | 3 | 3 | 4 | 1 | 0 | 0 | 1 | 1 | 2 |
| Endosome | 0 | 0 | 1 | 1 | 0 | 3 | 0 | 0 | 0 | 0 | 0 | 0 | 1 | 2 | 2 | 2 | 2 | 0 | 3 | 0 | 1 | 0 | 2 | 6 |
| Golgi | 0 | 0 | 0 | 0 | 1 | 0 | 0 | 0 | 0 | 0 | 0 | 0 | 0 | 0 | 0 | 1 | 1 | 1 | 1 | 1 | 0 | 0 | 0 | 1 |
| Mitochondria | 85 | 0 | 7 | 14 | 20 | 104 | 171 | 118 | 171 | 161 | 205 | 113 | 19 | 0 | 2 | 5 | 9 | 9 | 1 | 1 | 2 | 5 | 9 | 12 |
| Nucleus | 268 | 115 | 209 | 142 | 189 | 194 | 236 | 202 | 212 | 246 | 204 | 234 | 281 | 486 | 442 | 212 | 147 | 131 | 252 | 122 | 215 | 231 | 336 | 339 |
| Nuclear Periphery | 1 | 0 | 0 | 0 | 0 | 2 | 1 | 0 | 0 | 0 | 2 | 2 | 0 | 0 | 0 | 1 | 2 | 1 | 0 | 0 | 0 | 0 | 2 | 3 |
| Nucleolus | 1 | 0 | 0 | 0 | 0 | 0 | 1 | 1 | 3 | 2 | 3 | 4 | 1 | 1 | 0 | 0 | 0 | 4 | 3 | 1 | 0 | 4 | 23 | 23 |
| Peroxisomes | 0 | 0 | 0 | 0 | 0 | 0 | 0 | 0 | 0 | 0 | 0 | 0 | 0 | 0 | 1 | 0 | 0 | 0 | 0 | 0 | 0 | 0 | 0 | 0 |
| SpindlePole | 0 | 0 | 4 | 0 | 5 | 2 | 2 | 3 | 1 | 2 | 0 | 2 | 1 | 3 | 5 | 2 | 0 | 1 | 2 | 0 | 2 | 5 | 14 | 9 |
| Vac/Vac Membrane | 2 | 6 | 2 | 1 | 5 | 5 | 5 | 3 | 3 | 2 | 4 | 3 | 3 | 9 | 6 | 10 | 18 | 13 | 12 | 8 | 31 | 24 | 78 | 63 |
| Unique Cell Count | 287 | 124 | 232 | 168 | 225 | 259 | 314 | 264 | 293 | 313 | 286 | 268 | 334 | 571 | 540 | 229 | 176 | 155 | 288 | 139 | 266 | 285 | 491 | 485 |
| Labelled Cell Count | 361 | 125 | 241 | 180 | 250 | 341 | 454 | 366 | 423 | 446 | 468 | 384 | 350 | 580 | 550 | 243 | 191 | 173 | 288 | 139 | 266 | 285 | 491 | 485 |
Yeast GFP Assignment
Protein Abundance
| Screen | WT1 | WT2 | WT3 | RAP60 | RAP140 | RAP220 | RAP300 | RAP380 | RAP460 | RAP540 | RAP620 | RAP700 | HU80 | HU120 | HU160 | rpd3Δ_1 | rpd3Δ_2 | rpd3Δ_3 | AF100 | AF140 | AF180 |
|---|---|---|---|---|---|---|---|---|---|---|---|---|---|---|---|---|---|---|---|---|---|
| Mean Cell GFP Intensity (1e-4) | 4.4 | 6.2 | 5.4 | 5.3 | 5.3 | 4.1 | 4.0 | 4.4 | 3.7 | 4.0 | 3.6 | 4.1 | 5.6 | 6.0 | 5.9 | 8.0 | 7.6 | 7.2 | 5.7 | 5.5 | 6.3 |
| Std Deviation (1e-4) | 0.7 | 1.1 | 1.0 | 1.6 | 2.1 | 1.2 | 1.7 | 1.3 | 1.1 | 1.3 | 1.2 | 1.3 | 1.8 | 1.2 | 1.3 | 1.4 | 1.5 | 1.4 | 1.4 | 1.0 | 1.9 |
| Intensity Change (Log2) | – | – | – | -0.03 | -0.01 | -0.38 | -0.44 | -0.29 | -0.53 | -0.43 | -0.57 | -0.38 | 0.05 | 0.15 | 0.12 | 0.58 | 0.5 | 0.41 | 0.09 | 0.04 | 0.23 |
Localization Change
| Localization | RAP60 | RAP140 | RAP220 | RAP300 | RAP380 | RAP460 | RAP540 | RAP620 | RAP700 | HU80 | HU120 | HU160 | rpd3Δ_1 | rpd3Δ_2 | rpd3Δ_3 |
|---|---|---|---|---|---|---|---|---|---|---|---|---|---|---|---|
| Cortical Patches | 0 | 0 | 0 | 0 | 0 | 0 | 0 | 0 | 0 | 0 | 0 | 0 | 0 | 0 | 0 |
| Bud | 0 | 0 | 0 | 0 | 0 | 0 | 0 | 0 | 0 | 0 | 0 | 0 | 0 | 0 | 0 |
| Bud Neck | 0 | 0 | 0 | 0 | 0 | 0 | 0 | 0 | 0 | 0 | 0 | 0 | 0 | 0 | 0 |
| Bud Site | 0 | 0 | 0 | 0 | 0 | 0 | 0 | 0 | 0 | 0 | 0 | 0 | 0 | 0 | 0 |
| Cell Periphery | 0 | 0 | 0 | 0 | 0 | 0 | 0 | 0 | 0 | 0 | 0 | 0 | 0 | 0 | 0 |
| Cytoplasm | 1.7 | 1.6 | 1.0 | 0.2 | 0.9 | 0 | -0.4 | 0.2 | -1.6 | 1.9 | 2.8 | 3.6 | -1.9 | -0.7 | -0.4 |
| Endoplasmic Reticulum | 0 | 0 | 0 | 0 | 0 | 0 | 0 | 0 | 0 | 0 | 0 | 0 | 0 | 0 | 0 |
| Endosome | 0 | 0 | 0 | 0 | 0 | 0 | 0 | 0 | 0 | 0 | 0 | 0 | 0 | 0 | 0 |
| Golgi | 0 | 0 | 0 | 0 | 0 | 0 | 0 | 0 | 0 | 0 | 0 | 0 | 0 | 0 | 0 |
| Mitochondria | 2.4 | 2.7 | 0 | 0 | 0 | 0 | 0 | 0 | 0 | 1.5 | 0 | 0 | -0.6 | 1.1 | 1.4 |
| Nucleus | -1.7 | -1.9 | -4.4 | -4.4 | -4.0 | -5.1 | -3.6 | -5.3 | -1.0 | -2.0 | -1.9 | -2.9 | 0.9 | -2.0 | -1.6 |
| Nuclear Periphery | 0 | 0 | 0 | 0 | 0 | 0 | 0 | 0 | 0 | 0 | 0 | 0 | 0 | 0 | 0 |
| Nucleolus | 0 | 0 | 0 | 0 | 0 | 0 | 0 | 0 | 0 | 0 | 0 | 0 | 0 | 0 | 0 |
| Peroxisomes | 0 | 0 | 0 | 0 | 0 | 0 | 0 | 0 | 0 | 0 | 0 | 0 | 0 | 0 | 0 |
| SpindlePole | 0 | 0 | 0 | 0 | 0 | 0 | 0 | 0 | 0 | 0 | 0 | 0 | 0 | 0 | 0 |
| Vacuole | 0 | 0 | 0 | 0 | 0 | 0 | 0 | 0 | 0 | 0 | 0 | 0 | 2.4 | 4.3 | 3.8 |
External localization resources
Images






























Protein Concentration and Protein Localization Data
| R1 | R2 | R3 | ||||||||||||||||
|---|---|---|---|---|---|---|---|---|---|---|---|---|---|---|---|---|---|---|
| G1 Pre-START | G1 Post-START | S/G2 | Metaphase | Anaphase | Telophase | G1 Pre-START | G1 Post-START | S/G2 | Metaphase | Anaphase | Telophase | G1 Pre-START | G1 Post-START | S/G2 | Metaphase | Anaphase | Telophase | |
| Concentration | 0.8033 | 0.8717 | 0.6843 | -0.0528 | 0.8787 | 0.6676 | 1.8372 | 1.0035 | 1.1789 | 0.5785 | 0.8781 | 0.9759 | 0.8912 | 0.7737 | 0.6709 | 1.1709 | 0.6704 | 0.5569 |
| Actin | 0.0207 | 0 | 0.0025 | 0 | 0.01 | 0.0004 | 0.0428 | 0 | 0.0382 | 0.0008 | 0.0211 | 0.013 | 0.0155 | 0.0005 | 0.0001 | 0.0627 | 0.0257 | 0 |
| Bud | 0.0005 | 0 | 0.0004 | 0 | 0.0004 | 0 | 0.001 | 0 | 0.0003 | 0.0002 | 0.0001 | 0.0001 | 0.0005 | 0.0001 | 0.0002 | 0.0002 | 0.0001 | 0 |
| Bud Neck | 0.0011 | 0.0001 | 0.0015 | 0 | 0.0023 | 0.0004 | 0.0034 | 0.0001 | 0.0018 | 0.0003 | 0.0015 | 0.0007 | 0.0026 | 0.0001 | 0.0005 | 0.0012 | 0.0002 | 0.0005 |
| Bud Periphery | 0.0011 | 0 | 0.0007 | 0 | 0.0013 | 0 | 0.0025 | 0 | 0.0012 | 0.0001 | 0.0001 | 0.0001 | 0.0013 | 0.0002 | 0.0006 | 0.0003 | 0.0001 | 0.0001 |
| Bud Site | 0.0019 | 0.0003 | 0.0017 | 0 | 0.0017 | 0 | 0.0023 | 0 | 0.0014 | 0.0003 | 0.001 | 0.0001 | 0.002 | 0.0002 | 0.0003 | 0.001 | 0.0003 | 0 |
| Cell Periphery | 0.0002 | 0 | 0.0002 | 0 | 0.0003 | 0 | 0.0006 | 0 | 0.0013 | 0 | 0.0001 | 0 | 0.0004 | 0.0001 | 0 | 0.0001 | 0 | 0 |
| Cytoplasm | 0.0073 | 0.0003 | 0.0048 | 0 | 0.0006 | 0.0008 | 0.0137 | 0.0013 | 0.0032 | 0.0072 | 0.0184 | 0.0002 | 0.0075 | 0.0004 | 0.0029 | 0.0006 | 0.0016 | 0.0001 |
| Cytoplasmic Foci | 0.0055 | 0 | 0.006 | 0 | 0.0048 | 0 | 0.0319 | 0.0003 | 0.0086 | 0.0106 | 0.0152 | 0.0026 | 0.0197 | 0 | 0.0001 | 0.0086 | 0.0136 | 0 |
| Eisosomes | 0.0003 | 0 | 0 | 0 | 0.0001 | 0 | 0.0003 | 0 | 0.0002 | 0 | 0.0001 | 0 | 0.0002 | 0.0001 | 0 | 0.0002 | 0.0001 | 0 |
| Endoplasmic Reticulum | 0.0038 | 0 | 0.0015 | 0 | 0.0015 | 0.0003 | 0.0071 | 0 | 0.0068 | 0.0012 | 0.0007 | 0.0001 | 0.0049 | 0.0005 | 0.0001 | 0.0004 | 0.0003 | 0 |
| Endosome | 0.0237 | 0.0001 | 0.0143 | 0 | 0.0178 | 0.0002 | 0.0552 | 0.0001 | 0.0031 | 0.0194 | 0.0147 | 0.0019 | 0.0172 | 0.0005 | 0.0002 | 0.0349 | 0.0063 | 0 |
| Golgi | 0.0049 | 0 | 0.0041 | 0 | 0.0148 | 0 | 0.0058 | 0 | 0.0013 | 0.0014 | 0.0179 | 0.0021 | 0.0055 | 0.0001 | 0 | 0.0113 | 0.0051 | 0 |
| Lipid Particles | 0.0165 | 0 | 0.0052 | 0 | 0.0199 | 0 | 0.009 | 0 | 0.0031 | 0.0019 | 0.0121 | 0.0087 | 0.0188 | 0.0001 | 0 | 0.012 | 0.0142 | 0 |
| Mitochondria | 0.0096 | 0.0001 | 0.0061 | 0 | 0.0126 | 0.0003 | 0.0078 | 0.0002 | 0.0077 | 0.0012 | 0.0023 | 0.0013 | 0.0033 | 0.0078 | 0.0008 | 0.0041 | 0.0143 | 0.0001 |
| None | 0.0017 | 0.001 | 0.0005 | 0 | 0.0005 | 0.0001 | 0.0081 | 0.0019 | 0.0012 | 0.0006 | 0.0213 | 0.0002 | 0.0022 | 0.0002 | 0.0095 | 0.0004 | 0.0024 | 0 |
| Nuclear Periphery | 0.0286 | 0.0047 | 0.0198 | 0.0005 | 0.018 | 0.0041 | 0.0433 | 0.0071 | 0.0214 | 0.0088 | 0.0044 | 0.0005 | 0.0188 | 0.0081 | 0.0029 | 0.0033 | 0.0018 | 0.0006 |
| Nucleolus | 0.0088 | 0.01 | 0.009 | 0.0071 | 0.0284 | 0.0131 | 0.0085 | 0.005 | 0.0053 | 0.0025 | 0.0106 | 0.0077 | 0.0159 | 0.0045 | 0.0074 | 0.0053 | 0.0095 | 0.0098 |
| Nucleus | 0.8464 | 0.9759 | 0.8977 | 0.992 | 0.8412 | 0.9715 | 0.6983 | 0.9672 | 0.8779 | 0.9276 | 0.8218 | 0.9527 | 0.8417 | 0.9735 | 0.9718 | 0.8396 | 0.8822 | 0.9883 |
| Peroxisomes | 0.0034 | 0 | 0.0078 | 0 | 0.0116 | 0 | 0.004 | 0 | 0.001 | 0.0029 | 0.0111 | 0.0066 | 0.0099 | 0 | 0.0001 | 0.0043 | 0.0172 | 0 |
| Punctate Nuclear | 0.0077 | 0.0072 | 0.0107 | 0.0002 | 0.0067 | 0.0086 | 0.0407 | 0.0166 | 0.0114 | 0.0117 | 0.0248 | 0.0013 | 0.0054 | 0.0022 | 0.0019 | 0.0013 | 0.0044 | 0.0004 |
| Vacuole | 0.0032 | 0.0001 | 0.0021 | 0 | 0.0029 | 0.0001 | 0.009 | 0.0001 | 0.0023 | 0.0009 | 0.0005 | 0.0001 | 0.0048 | 0.0004 | 0.0004 | 0.0064 | 0.0002 | 0.0001 |
| Vacuole Periphery | 0.0032 | 0 | 0.0035 | 0 | 0.0025 | 0.0001 | 0.0048 | 0.0001 | 0.0013 | 0.0005 | 0.0002 | 0.0001 | 0.002 | 0.0003 | 0.0001 | 0.0018 | 0.0002 | 0 |
Sequencing Data
| R1 | R2 | |||||||||
|---|---|---|---|---|---|---|---|---|---|---|
| G1 Post-START | S/G2 | Metaphase | Anaphase | Telophase | G1 Post-START | S/G2 | Metaphase | Anaphase | Telophase | |
| Gene Expression | 4.868 | 8.7033 | 11.4813 | 11.8569 | 12.623 | 8.6494 | 10.2666 | 11.8787 | 9.9898 | 10.1797 |
| Translational Efficiency | 2.774 | 1.4296 | 1.2138 | 1.2852 | 0.8624 | 1.5158 | 1.1089 | 0.7008 | 1.083 | 0.9248 |
Hit Data
| Dataset | Hit |
|---|---|
| Protein Concentration | ✘ |
| Protein Localization | ✘ |
| Gene Expression | ✘ |
| Translational Efficiency | ✘ |
Endocytosis
| Temp | Actin Patch (Sac6-tdTomato) | Cortical Patch (Sla1-GFP) | Late Endosome (Snf7-GFP) | Vacuole (Vph1-GFP) |
|---|---|---|---|---|
| 37℃ | ||||
| RT |
Cell Cycle Omics
CYCLoPs (Cwc2-GFP)
| Gene / Allele | Actin Patch (Sac6-tdTomato) | Cortical Patch (Sla1-GFP) | Late Endosome (Snf7-GFP) | Vacuole (Sac6-tdTomato) |
|---|
| Gene | Images |
|---|
| Gene | Images |
|---|
Images are not yet available
Images are not yet available